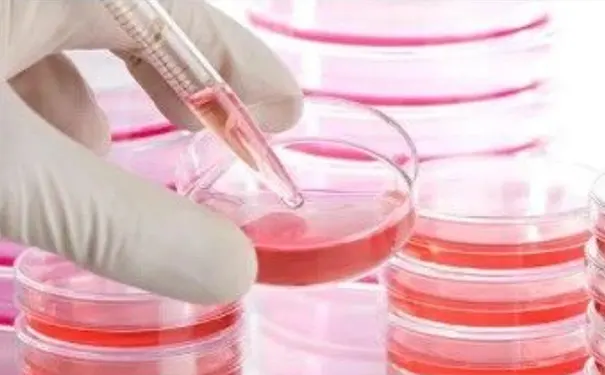
杭州博养压疮治疗中心

发布时间:2025-12-24 浏览量:0
创面愈合是一个复杂而有序的生物学过程,主要包括炎症反应,细胞增殖/结缔组织形成面收缩和创面重塑几个阶段。愈合过程的各个阶段涉及多种炎症细胞,修复细胞,炎症介质,细胞因子和细胞外基质等成分的共同参与。创面愈合过程在机体的协调下现高度的有序性,完整性和网络性。任何因素导致创面愈合的任何环节出现异常,都有可能导致创面的延迟愈合或不愈合
炎症反应是机体对组织损伤或致病因子侵入的基本反应。其作用在于杀灭侵入的微生物,清除异物及自身伤亡细胞,坏死组织,防止感染及损伤的扩大,以利组织的再生与修复,同时炎症细胞分泌多种细胞因子诱导修复细胞的迁徙,增殖,启动并调控创面修复过程,是组织修复的基础。

炎症反应是在多种细胞成分参与,多种炎症介质调控下的复杂的生物学反应。炎症反应过程中炎症介质的激活和释放是机体对于损伤或致病因子的一种保护性应答,但炎症介质本身是一把"双刃剑",适度的炎症反应可发挥防御的功能,诱导创面的有序修复。炎症反应低下不仅容易造成病原微生物感染难以控制,而且可导致细胞增殖等后续修复阶段的延迟或减弱,形成创面愈合延迟的结局。而过度炎症反应却可通过长时间或过量释放炎症介质及分解酶类加重局部组织损伤,甚至可导致成人呼吸窘迫综合征,全身炎症反应综合征等全身性并发症的发生,使患者一般情况恶化,创面愈合延迟。因此,炎症反应过度或低下均可导致慢性创面的发生。

常见的慢性创面中,放射性皮肤组织溃疡和糖尿病创面均可见到灾证反应异常。放射性溃疡由于局部微血管损伤和闭塞,炎症细胞渗出,游走发生障碍,使得局部炎症反应低下,加之广泛的组织修复细胞受到放射性损伤,形成难以愈合的慢性创面。而糖尿病皮肤组织的炎症异常表现为不一样的特征。在未创伤的糖尿病皮肤中可见到局灶性的炎性细胞浸润,创伤后,炎症细胞进人创面的时间延迟,但在创面中数量增加,停留时间延长,且炎症细胞呈现弥散分布特征,而非正常创伤后所见的炎症反应带。迁延弥散的炎症反应不仅不能有效地清除坏死组织和抵抗感染侵袭,反而易于造成正常组织受损,同时不利于启动后续的组织修复程序。
氧自由基等活性氧成分通过脂质过氧化作用,破坏DNA结构,氧化蛋白质中的巯基基团,及降解细胞外基质成分,破坏细菌关键成分,最终导致细胞死亡。适度的氧自由基对消灭外来致病物,清除损伤变性组织,细胞中同样起关键作用。但过量的自由基则可导致组织处于氧化应激状本引起组织据伤"氧化应激"具指机体在遭受各种有害刺激时,体内高活性分子如活性氧自由基和活性氮自由基产生过多,氧化程度超出氧化物的清除,氧化系统和抗氧化系统失衡,从而导致组织损伤。很多因素如糖代谢素乱及射线损伤等均可导致组织的氧化应激状态。研究证实,无论是糖尿病皮肤损伤,还是放射性皮肤组织损伤,抗氧化治疗均取得满意的疗效。
在皮肤组织中,基底层表皮细胞不断增殖,分化并向上迁移,最终成为角质层细胞从皮肤表面脱落,表皮细胞的增殖维持着表皮的正常结构和生理功能。因此,表皮细胞的增殖正常与否对于维护机体功能以及在受到创伤后创面的顺利愈合,起着极为重要的作用。正常的细胞增殖依赖于细胞增殖周期的顺利完成,否则将导致细胞增殖障碍,影响上皮化过程。很多因素如糖尿病及放射线均可导致表皮细胞增殖受抑。研究发现糖尿病皮肤中处于S期和 G2/M期的表皮细胞显著减少,呈现明显的增殖障碍。这一发现与糖尿病皮肤中存在表皮层明显变薄的组织学改变相吻合,是糖尿病皮肤易破损及不易上皮化的原因之一。
成纤维细胞是重要的修复细胞之一。它通过迁移,增殖,分化,分泌胶原和各类细胞因子对创伤修复起作用。成纤维细胞的主要功能是合成分泌细胞外基质,填补组织缺损。成纤维细胞功能异常是创面难愈的重要原因之一。研究发现,射线可引起成纤维细胞过度分化,使前体成纤维细胞分化到终末成纤维细胞的周期大大缩短,从而导致前体细胞和终末分化细胞的比例改变(正常情况下两者之比为2:1)而终末分化的成纤维细胞分泌细胞外基质如各型胶原的能力远高于前体细胞。射线导致成纤维细胞变化引起的组织稳态失衡,是导致组织纤维化发生的基础之一。射线对成纤维细胞的改变可能是永久性的,此类终末分化的成纤维细胞增殖分化能力下降,凋亡速率加快,其分泌胶原的能力低于正常的成纤维细胞,或者生成的胶原不能快速成熟以适应创面愈合的需要,从而影响修复质量。糖尿病皮肤组织中成纤维细胞的功能异常与皮肤组织中糖代谢产物的蓄积有关,并且呈剂量依赖性。

血管内皮细胞衬覆于血管内壁,是构成血管壁通透性的主要屏障,能合成和分泌调节凝血-纤溶系统的物质及调节血管张力的因子,参与免疫反应。在血管形成,创面愈合和胚胎发育中起重要作用。内皮细胞功能障碍将引起血液循环系统的变化。影响创面愈合。
血管内皮细胞增殖和凋亡之间的平衡与血管稳态的维持及血管重建密切相关。正常情况下,创伤会刺激血管内皮细胞表现出增殖倾向,但某些有害刺激,如放射线,糖尿病糖代谢产物异常蓄积,常导致内皮细胞增殖受抑,凋亡增加,内皮细胞形态亦发生变化,失去鹅卵石样排列结构,细胞间空隙增大。内皮细胞的凋亡在诸如动脉硬化,同种异体移植血管病,高血压血管病中扮演重要角色。在创面愈合中内皮细胞增殖受抑,凋亡率的增高是影响新生血管形成的原因之一。
正常情况下,血管内皮细胞与白细胞的黏附率较弱,在血管内形成一个平衡稳态,当内皮细胞受到有害因素刺激时,其表面黏附分子的表达增加,介导白细胞的贴壁,黏附,一方面可增加血栓形成的风险。创缘部位微血管的栓塞可导致创面局部的坏死,创面加深;另一方面,有害因素刺激常导致内皮细胞受损,血管通透性增加,内皮细胞表面黏附分子的表达有利于白细胞向组织间隙的渗出和游走,引起非创伤组织呈现出在创伤状态下才有的炎症反应。常见的损伤刺激包括放射线的直接损伤,糖代谢素乱引起的代谢产物(如AGEs)的蓄积,以及高浓度自由基引起的细胞损伤。
正常情况下,血管内皮分泌调节血管张力的因子,调节血管舒缩功能。在某些病理条件下(如糖尿病),内皮细胞分泌调节血管张力的因子下降,导致血管舒缩功能改变,局部微循环的调节功能减退,使血循环量增加和动静脉间短路开放,营养血管血流明显减少,组织缺血,缺氧严重,正常代谢难以维持,出现皮肤大瘤和自发性溃疡。

创面愈合的各个阶段都有生长因子的参与和调控。生长因子调控细胞趋化,活化,增殖,分化和移行,最终完成创面修复。生长因子表达量的下降或生长因子活性的变化,可能影响细胞增殖,分化,合成功能,使创面愈合过程延长。研究发现,糖尿病皮肤组织因糖代谢产物(如AGEs)的逐渐累积,持续作用于细胞导致其合成和分泌生长因子(如 IGF-1等)的能力下降,使创面局部某些生长因子缺乏或不足。生长因子糖基化可使生长因子活性改变,促有丝分裂的活性显著降低,可能是血管形成障碍的基础之一。外源性应用生长因子可促进创面愈合进一步佐证了这一点
细胞外基质不仅为机体所有主要器官提供了构架组织,也为细胞的增殖,迁移,分化及细胞间相互作用提供了功能性基质,这些相互作用在机体发育,创面愈合和保持组织完整性方面至关重要。胶原是ECM的主要成分,其主要作用是维持组织的完整性和形态结构。皮肤组织中胶原主要由成纤维细胞合成,多种细胞因子参与胶原合成的调控。成纤维细胞自身的损伤或细胞因子的不足抑或活性改变可引起胶原合成的下降。基底膜的糖基化可以影响内皮细胞和单核-巨噬细胞正常的形态,增殖,移动和分化。因此胶原的合成量的下降,合成/降解的失衡或交联的缺陷等均可能引起创面延迟愈合或不愈合。

慢性难愈创面的形成常不是单一因素造成的,损伤因素常常累及到创面修复的各个环节,相互影响,相互作用,且这些影响因素往往在创面形成之前即已长期存在,并最终造成皮肤组织的异常改变,成为慢性创面面形成的发病基础,进而导致创面难愈甚至不愈。
以上是有关慢性创面愈合延迟的机制,下期将继续为大家讲述糖尿病足治疗相关的内容。